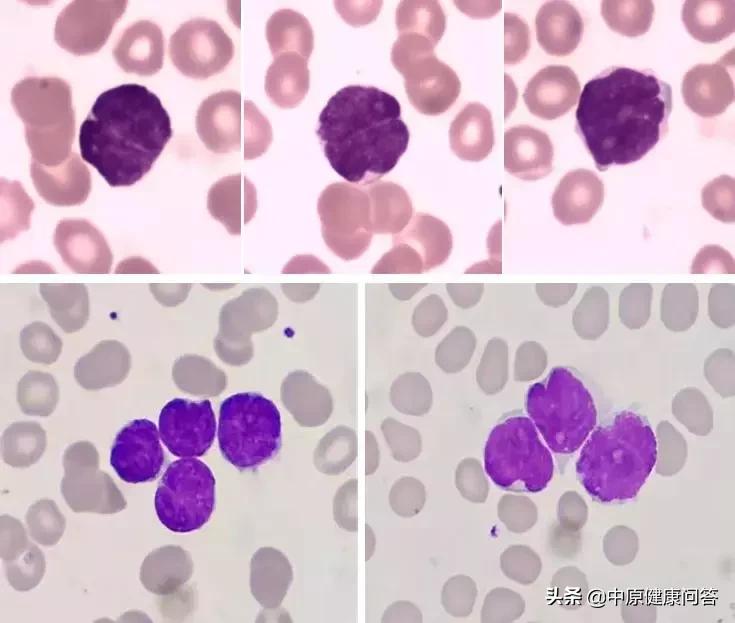
小小血常规,隐藏大奥秘

提起血常规,大家的第一印象就是“哦,感冒了呀,查个血常规,看看是细菌性的还是病毒性的”。其实,一张小小的血常规报告单不仅能够向我们展示白细胞计数的高低及各类白细胞的比例、是否贫血、血小板多少,只要我们用心去观察,还能深挖其中潜藏的问题。
一张完整的血常规报告单,包括两部分,一部分是数字报告,通过上、下箭头的提示,很容易看出哪部分不正常。比如大家惯性认为的白细胞数高了,中性分叶粒细胞比例也明显增高,那就是细菌感染,该用消炎药了;反之如果白细胞数未见明显增减,淋巴细胞比例增高,则认为是病毒性的。一般来说可以这么理解,但还要具体问题具体分析。
一张完整的血常规报告单的第二部分,就是散点图和直方图,这是一直被大家忽略的部分,但恰恰又是最重要的部分,数字报告显示的是血细胞量的多少,而散点图和直方图则提示细胞形态的正常否。如果数字报告上有很多上上下下的箭头,而散点图是正常的话,那这份血常规的细胞形态是没什么问题的;反之,如果数字报告全部在正常范围,而散点图有异常的话,则一定要涂片镜检,因为很可能细胞形态有异常。下面就来带大家看一个病例:

对于这份报告单,数字报告部分有异常的已经向大家展示出来:病人轻度贫血、血小板轻度减低,淋巴细胞比例有所增高。但结合病人病史--脑内出血,又能解释的通,既然出血红细胞肯定有消耗,机体启动凝血机制对血小板也有一定的消耗。那么现在还有一个淋巴细胞比例增高的问题,除此之外,大家还发现异常了么?
对,散点图,散点图,散点图,重要的事情说三遍,在审核血常规报告单时,一定要把散点图时刻放于心中。

病人散点图(左)正常散点图(右)
和正常人血常规散点图相比,病人的紫红色的淋巴细胞和绿色的单核细胞散点图串在了一起,这就是异常。一般来说,散点图上的四群细胞(嗜碱粒细胞有专门的通道)颜色分明,区域清晰,既不会串色,也不会串门儿。既然发现了异常,首要任务就是推片镜检。
在镜下,发现了一群形态怪异的淋巴细胞,不仅单个散在,还有呈簇分布的,这类细胞胞浆量少,胞核似大脑样分瓣儿,染色质粗糙,可见核仁(此类细胞占有核细胞的35%)。当看到这类细胞时,我们的第一感觉就是病人肯定不止脑出血那么简单,这个形态怎么那么像淋巴瘤呢?!赶快和临床大夫电话沟通,建议血液科会诊。之后,病人转至血液科做进一步检查,考虑到年龄问题,抽取了外周血进行流式细胞学检查。

结果出来以后,不出我们意料--B细胞淋巴瘤侵犯外周血。接下来就是临床的对症治疗,病例部分到此结束。但就是这么一个简单的病例,通过一个小小血常规结果,我们发现了异常,并向临床做出了警示,提示这个病人有可能不止一种病症(当然有时候恶性淋巴瘤侵犯脑实质也可引起脑出血),既诊断清楚了病症,又规避了医患纠纷的风险。
由此,我心生感慨,做打油诗一首:
检验人员有慧眼
发现图形有疑点
推片查找其根源
怪异淋巴镜下现
对于我们检验人,打交道最多的就是病人的标本,病人的病情怎么样,查体如何,有无其他病症,我们一概不知。之前有人笑话检验人员就是熟练操作工,上机、下机、发报告三部曲的机械操作,所以有医技部门是临床的附属物是说。但是,现在对于我们科室来说,主任重视形态学的发展,同事们对形态学热情高涨,而且我们的主管院长谢院长每次查房都会关注细胞室,并向我们提一些发展建议,使得我们干劲十足。现在,我们每天的血常规镜检率高达15%,从散点图上发现的问题不在少数,为病人的精准诊断贡献了力量,也得到了临床医生的一致好评。在科室主任的带领下,我们检验者不再是临床的附属,而是临床的合作伙伴和沟通桥梁。在2019年,我们会启动河南省体液细胞学检验论坛,继续开展具有特色的体液细胞学检测,引进更多的细胞学检测项目,满足各临床专业需求,争取成为开封市重点专科。
文字 | 检验科 刘妍 李相磊
图片 | 检验科 刘妍 李相磊